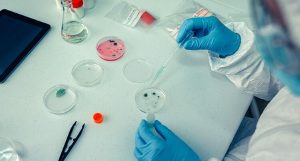
Hình ảnh minh họa kiểm nghiệm vi sinh trong phòng thí nghiệm

Tin tức
Tin tức MT là nơi cập nhật những kiến thức chuyên sâu và thông tin mới nhất về vi sinh, công nghệ sinh học và thiết bị phòng thí nghiệm. Tại đây, bạn sẽ tìm thấy các bài viết phân tích chuyên môn về quy trình nuôi cấy, công nghệ lên men, kiểm soát vi sinh vật trong thực phẩm, cũng như hướng dẫn lựa chọn thiết bị đạt chuẩn cho phòng lab và dây chuyền sản xuất. Nội dung được biên soạn bởi đội ngũ kỹ thuật của MT, giúp doanh nghiệp và phòng thí nghiệm nâng cao hiệu quả vận hành và tiếp cận các giải pháp công nghệ hiện đại.
Vai trò của màng lọc vi sinh trong hệ thống bioreactor
Các ngành công nghiệp sinh học, dược phẩm và thực phẩm ngày càng đặt ra...
Thiết bị phòng sạch là gì? Tiêu chuẩn kỹ thuật cần biết
Thiết bị phòng sạch đóng vai trò then chốt trong việc duy trì môi trường...
Sự khác biệt dung môi phân cực và không phân cực thế nào?
Dung môi phân cực và dung môi không phân cực là hai khái niệm quan...
Tủ cấy vi sinh là gì? So sánh các loại tủ cấy vi sinh
Trong nghiên cứu khoa học và y sinh học hiện đại, việc duy trì môi...
Các thiết bị lọc vi sinh tiêu chuẩn cho Bioreactor
Kiểm soát điều kiện vô trùng là yếu tố quyết định đến chất lượng của...
Tổng số vi sinh vật hiếu khí trong thực phẩm: Ý nghĩa và giới hạn
Trong chuỗi sản xuất thực phẩm, tổng số vi sinh vật hiếu khí trong thực...
Khoáng đa lượng và khoáng vi lượng trong nuôi cấy mô
Nhiều hệ thống nuôi cấy mô thất bại không phải do giống mà do môi...
Môi trường PDA trong nuôi cấy vi sinh vật
Lựa chọn môi trường nuôi cấy phù hợp đóng vai trò quyết định đến sự...
Môi trường MS trong nuôi cấy mô thực vật
Việc lựa chọn môi trường dinh dưỡng phù hợp quyết định đến 80% sự thành...
Các loại Enzyme được sử dụng trong chế phẩm sinh học hiện nay
Các loại Enzyme chế phẩm sinh học ngày càng được ứng dụng rộng rãi trong...
Công nghệ Enzyme: Quy trình và ứng dụng trong đời sống
Cùng với sự phát triển của công nghệ sinh học hiện đại, enzyme ngày càng...
Ứng dụng vi khuẩn lên men trong sản xuất chế phẩm sinh học
Ứng dụng vi khuẩn lên men trong sản xuất chế phẩm sinh học đang được...